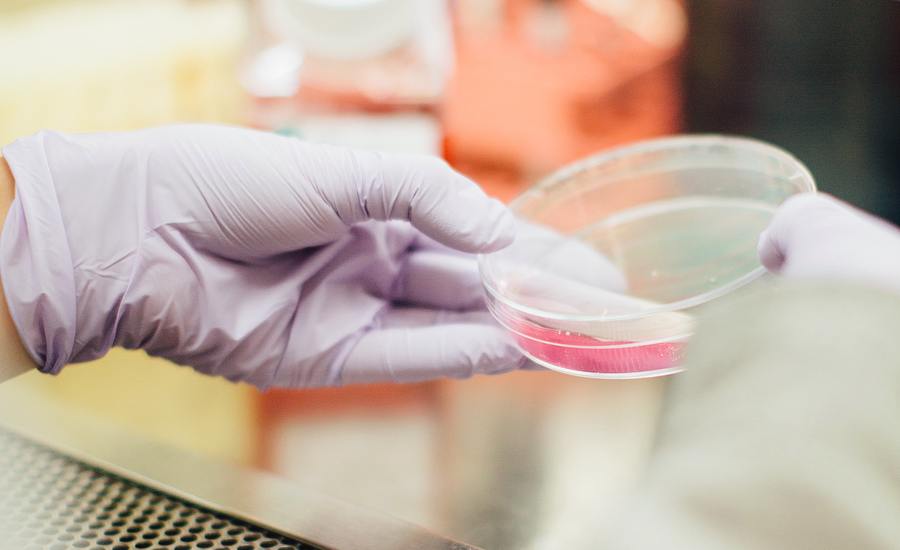

Van laptop naar ziekenhuis: hoe passen we AI toe op de praktijk?
Wynand Alkema over data science- Onderzoeker aan het woord


Je kunt er tegenwoordig niet omheen: AI gaat onze levens – en banen – veranderen. Dat geldt ook voor zorgverlening, diagnostiek, medicijnen en voeding. Maar hoe gaat dit in zijn gang? Om dit te begrijpen praten wij met Wynand Alkema, lector Data Science for Life Sciences and Health. Zijn advies? "Je moet altijd domeinkennis hebben en altijd in gesprek gaan met mensen uit het veld: wat wil je, wat doe je, hoe ziet je werk eruit? Vervolgens moet je de datamogelijkheden in je achterhoofd houden en deze twee werelden combineren."
Hoe maakt AI-onderzoek de stap van laptop naar ziekenhuis? Wynand legt het ons uit. Maar…eerst de basics:
Voor de een is het een wondermiddel, voor de ander het einde van de mensheid. Maar wat is AI eigenlijk? "Het is een benadering van hoe een mens denkt, maar dan door een machine. Het recreëert de gedachteprocessen, zoals het combineren van feiten en trekken van conclusies zoals een mens dat zou doen," legt Wynand uit. Mensen leren namelijk van eerdere ervaringen. We herkennen patronen: iedere keer als A gebeurt, gebeurt B ook. "Nou, dit doet artificial intelligence eigenlijk ook."
Deze ervaringen noem je in de context van AI input. Na een tijdje kan een AI-model op basis van input gevolgen voorspellen – deze gevolgen noemen we output. Hoe meer voorbeelden je geeft aan zo’n model, hoe beter het leert (net als een mens). Dit heet het trainen van het model. Dit wordt gedaan door een data scientist. Een data scientist zorgt ervoor dat het model de juiste inputs krijgt, en analyseert de outputs. “Het is net als wanneer je een kind of een leerling iets leert. Je bent als leraar bezig om te zorgen dat ze de juiste lesstof krijgen, en je gaat vervolgens toetsen of het wel allemaal goed begrepen is.”
Slechte of incomplete lesstof betekent ook slechte resultaten. Kunstmatige intelligentie faalt namelijk op dezelfde manier als menselijke intelligentie faalt; het kopieert onze blinde vlekken en vooroordelen. “Zo zijn er veel voorbeelden waar, vaak ook door onwetendheid, de verkeerde inputdata gebruikt worden en ook de verkeerde outputdata, waarbij je een model krijgt die niet geschikt is. Vervolgens worden modellen getraind op hun eigen output, en dan krijg je een versterkend effect van de fout die er in het begin is ingeslopen.”

Wynand richt zich in zijn lectoraat Data Science for Life Sciences and Health op data in de biowetenschappen. Denk daarbij aan gezondheid, medicijnen en diagnostiek, maar ook aan voeding. Maar hoe werkt dit eigenlijk? Hoe kan een computersysteem of AI-algoritme een arts helpen bij het herkennen van symptomen, of het ontwikkelen van gezonde voeding?
“Je gebruikt dezelfde technieken, maar de voorspellingen die je wilt doen, doe je op gebied van life sciences. Je kunt nu vragen beantwoorden zoals: ‘is dit medicijn gepast voor deze patiënt?’ of ‘als ik dit bloedbeeld zie van een patiënt is dat een indicatie dat hij zieker wordt of juist aan de beterende hand is?’ of ‘zou dit nieuwe ingrediënt werken in dit recept?’”

Laten we medische vraagstukken als voorbeeld nemen. AI gebruikt grote hoeveelheden data om patronen te herkennen en verbanden leggen die voor het menselijk brein niet te bevatten zijn. Denk bijvoorbeeld aan data over ziektebeelden van duizenden patiënten met dezelfde soort kanker. “Zo zijn er databases waarin duizenden metingen zijn bij patiënten met een bepaald type kanker, en ook bij gezonde mensen. Dan kun je deze twee groepen met elkaar vergelijken en, heel simpel gezegd, vragen ‘welk stukje input komt altijd over met de output, de diagnose kanker?’”. Met AI kunnen we snel al deze data verwerken om conclusies te trekken. Dit kan leiden tot de ontwikkeling van nieuwe diagnostische tests en gepersonaliseerde behandelingen. Maar er zijn ook valkuilen: hoe waarborgen we de kwaliteit van de data, hoe is deze data vastgelegd, en is de metadata (informatie over de karakteristieken van de data) wel compleet? In veel gevallen moeten onderzoekers gebruik maken van publieke data, of data zelf genereren.
Grote aantallen data genereren is lastig bij mensen, maar dit wordt simpeler wanneer je met andere organismen werkt, zoals bacteriën. Wynand werkt bijvoorbeeld samen met lector Janneke Krooneman. Janneke doet onder andere onderzoek naar de productie en afbraak van het biopolymeer PHA door bacteriën. Waar kan je AI voor gebruiken bij bacteriën? “Stel, je hebt een aantal bacteriën die bioplastic afbreken, en aantal bacteriën die dat niet doen. Met AI kun je duizenden kenmerken van deze bacteriën meten en vergelijken – handmatig is het niet te onderzoeken welke factoren correleren met plastic afbraak en welke niet.” Het onderzoek van Wynand ondersteunt het onderzoek van Janneke en andere onderzoekers in het kenniscentrum door voorspellingen te maken: “Zo kunnen we onderzoekers die hier op het lab werken voeden met de activiteiten die een hogere kans van slagen hebben dan die een lagere kans van slagen hebben. Dit betekent minder proefjes die mislukken en minder afval, maar ook snellere implementatie van onderzoeksresultaten in de praktijk.”
De toepassingsmogelijkheden zijn oneindig en lijken veelbelovend, maar waar begin je? Volgens Wynand moet je bij de praktijk beginnen: “Je begint met de vraag: wat is het probleem dat ik op wil lossen? Bijvoorbeeld als we het hebben over een bedrijf: wat is het punt waar het productieproces spaak loopt?” Als je het probleem hebt gevonden, kan je naar de volgende stap: welke data heb ik nodig om een oplossing te vinden voor dit probleem?
Een voorbeeld: een waterbedrijf wil voorspellen waar de pompen het eerste kapot zullen gaan. Met deze kennis kunnen ze namelijk hun onderhoud op het de zwakste schakel focussen. Dan moet je aan alle factoren denken: data over de pompen, data over wanneer de pompen het meest gebruikt worden, waar de pompen eerder kapot zijn gegaan, etc. Heb je niet genoeg inputdata (informatie over de pompen en de omgeving) of outputdata (informatie over de gevolgen voor de pompen zoals lekkage of schade), dan kan je geen model trainen. Vervolgens is er nog de businesscase om te overwegen. Welke investering kost dit model? Wat levert het op als dit probleem oplossen?
Als je businesscase goed in elkaar zit, hoe ga je het verder in de praktijk toepassen? Zouden medewerkers of klanten het model wel gebruiken? Niet elk model is een succes. Wynand: “Van de 3000 modellen die er in het wetenschappelijk domein zijn om diagnoses te stellen bij een patiënt, is er maar één die het redt in de kliniek.” Alle andere modellen sluiten niet aan op de praktijk.
Daarom is Wynands advies om gedurende het hele proces met de professional samen te werken: “Je moet naast de arts gaan staan, naast die boer, of naast die verpleegkundige, en zeggen: ‘hoe werk jij? Hoe ziet jouw computerscherm eruit? Hoe werkt jouw proces? Als ik iets voor jou kan betekenen, waar in dat proces kan ik jou dan helpen?’” Dit vergemakkelijkt de acceptatie; de oplossing is namelijk samen ontwikkeld. Oftewel:

AI is al aanwezig in ons dagelijks leven. Denk aan de algoritmes in je social media apps die je gebruik analyseren en nieuwe content aanbevelen. Language models, zoals ChatGPT, waren er ook al. Wat de recente golf aan AI-applicaties onderscheidt is dat het generatief is: het maakt nieuwe content. Daarnaast is het nu heel makkelijk en toegankelijk gemaakt, door een goede interface eromheen te bouwen. “Voor mensen in het veld was het niet nieuw. Toch werd je in een keer geconfronteerd met hoe krachtig het is. Ik was daar ook door verrast.” Het gemak van ChatGPT onderstreept hoe belangrijk de klant of de gebruiker is bij de ontwikkeling van AI.
Wat voor ontwikkelingen kunnen we nog meer verwachten? “Waar gaat het heen? Dat durf ik echt niet te zeggen.” Wel is het duidelijk dat het hard gaat, waardoor veel studenten en professionals nerveus worden over de toekomst van hun banen. Als je mee wil liften met de AI-golf, hoe pak je dan aan? Waar focus je je op? En kun je wel concurreren met de Silicon Valley giganten? “In de toekomst moeten we meer op zoek naar de niches,” legt Wynand uit.
“We moeten kijken naar wat er al mogelijk is, wat er al ligt, en wat de need van de klant of de gebruiker is, of het nou een boer, een dokter, of een softwareontwikkelaar is. We moeten inzetten op het spreken van twee talen. De wiskunde van de data, en de taal van de gebruiker, het doorgronden van de vraag van de klant.” Daar kan je waarde toevoegen, en dat is waar Wynands onderzoeksgroep zich op richt. “Je moet je interesseren voor de processen die je wilt verbeteren. Daar hoort ook bij dat je domeinkennis nodig hebt. Daarom doen wij [in onze onderzoeksgroep] eigenlijk ook geen AI voor energiebeheer of voor webshops of die wereld. Wij doen AI voor life sciences – en dat is al heel breed.”

Wat de toekomst zal brengen is onduidelijk. Wat wel duidelijk is, is dat data scientists twee talen moeten spreken: datataal en gebruikerstaal. Met deze vaardigheid kunnen ze niet alleen zorgen voor goede implementatie van AI, maar ze kunnen ook invloed hebben op hoe AI wordt toegepast. Ze kunnen bijvoorbeeld meepraten bij gesprekken over ethische vraagstukken, misinformatie of veiligheid. Ze kunnen meer duidelijkheid geven over wat AI wel en niet kan. Tenslotte kunnen ze een ambassadeur zijn voor verantwoordelijk gebruik van AI (bijvoorbeeld in het kader van de klimaatimpact van AI, omdat het trainen van modellen een energieslurpend proces is). Net zoals elke tool kan AI gebruikt worden ten goede van de samenleving. Oftewel: de data scientists zijn aan zet.
Het lectoraat Data Science for Life Sciences and Health onderzoekt en ontwikkelt nieuwe ingrediënten en duurzame voeding in een biobased economie.
Lees er meer overHoe tevreden ben jij met de informatie op deze pagina?